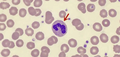

子宫腺肌症患者怀孕几率有多少,详解怀孕后的注意事项
0人评论 9319次阅读 发表于2021年11月9日 19:08:05
子宫腺肌症患者怀孕的几率是非常低的,但是还是有一定的几率可以怀孕,建议子宫腺肌症患者先接受治疗,等治疗成功之后再准备怀孕,因为子宫腺肌症[1]患者怀孕是有一定的风险性的,有可能会导致产后出血等症状,所以一定要及早治疗。
名称
子宫腺肌症
科室
妇科
能否怀孕
能
怀孕风险
腹痛、产后大出血
子宫腺肌症的怀孕几率
子宫腺肌症怀孕是很难的,甚至子宫腺肌症会导致30%~50%的患者失去怀孕功能,子宫腺肌症会使子宫角附近发生病变,就会压迫输卵管的开口处,是卵子发生堵塞,如果压迫子宫颈部,那么就会改变子宫颈口的朝向,从而阻碍子宫颈管,使它远离后窟窿补位的精液池,精子无法进入子宫颈口,并且子宫腺肌症还会影响子宫收缩的幅度、持续时间已经频率,这会导致受精卵不能着床,着床之后也有很大的几率会发生流产。
但是并不是所有的子宫腺肌症都会影响怀孕的,这个主要看子宫腺肌症发生的补位,以及患者的症状程度,如果检查之后发现可能会影响怀孕,那么就应该及时接受治疗,治疗成功之后,仍然是可以正常怀孕的。
子宫腺肌症怀孕的风险
子宫腺肌症[2]患者是不建议怀孕的,要想怀孕应该在病情治愈之后再开始备孕,因为子宫腺肌症怀孕是有一定的风险性的,具体如下:
一、流产
- 因为病症会导致子宫收缩问题,很容易导致早期发生流产。
二、腹痛
- 腺肌症病灶本身就很容易发生病变,再加上子宫收缩,很容易导致腹痛发生。
三、产后大出血
- 因为子宫腺肌症患者在分娩过程中,很容易引起子宫收缩乏力,导致产力不协调,就会引起分娩之后发生大出血。
以上这三点就是子宫腺肌症患者怀孕后的风险了,所以还是建议各位子宫腺肌症患者一定要及早治疗,在患病过程中怀孕不管是对自己还是对胎儿都有非常不利的影响。
子宫腺肌症怀孕注意事项
子宫腺肌症是会影响怀孕的,如果子宫腺肌症患者出现了自然怀孕的情况,平时一定要多注意保胎细节,因为子宫腺肌症[3]患者很容易流产的,在饮食方面要多加注意,尽量吃一些营养丰富、低脂肪的食物,比如蔬菜水果等,并且要增加产检次数,多观察胎儿和自身的情况,这样才能确保胎儿和自身有一个良好的保障。
参考资料
1.刘梁子综述, 任雅梦综述, 史小荣审校.《有生育要求子宫腺肌症的保守治疗》.临床与病理杂志
[引用日期
2021-11-07]
2.周应芳, 麦永嫣, 郑淑蓉.《子宫腺肌症的发病原因和诊治研究进展》.中华妇产科杂志
[引用日期
2021-11-01]
3.刘玉红.《子宫腺肌症的MRI表现及诊断价值》.现代诊断与治疗
[引用日期
2021-11-01]
如果您对该内容存疑,请点击右侧纠错
纠错
免责声明:
孕小帮上所有内容均出于传递更多信息之目的,并不意味着赞同其观点或证实其描述。
任何关于疾病的建议都不能替代执业医师的面对面诊断,请谨慎参阅。本站不承担由此引起的法律责任。
做第一个评论的人吧~
相关文章
找医院
子宫腺肌症
20篇文章